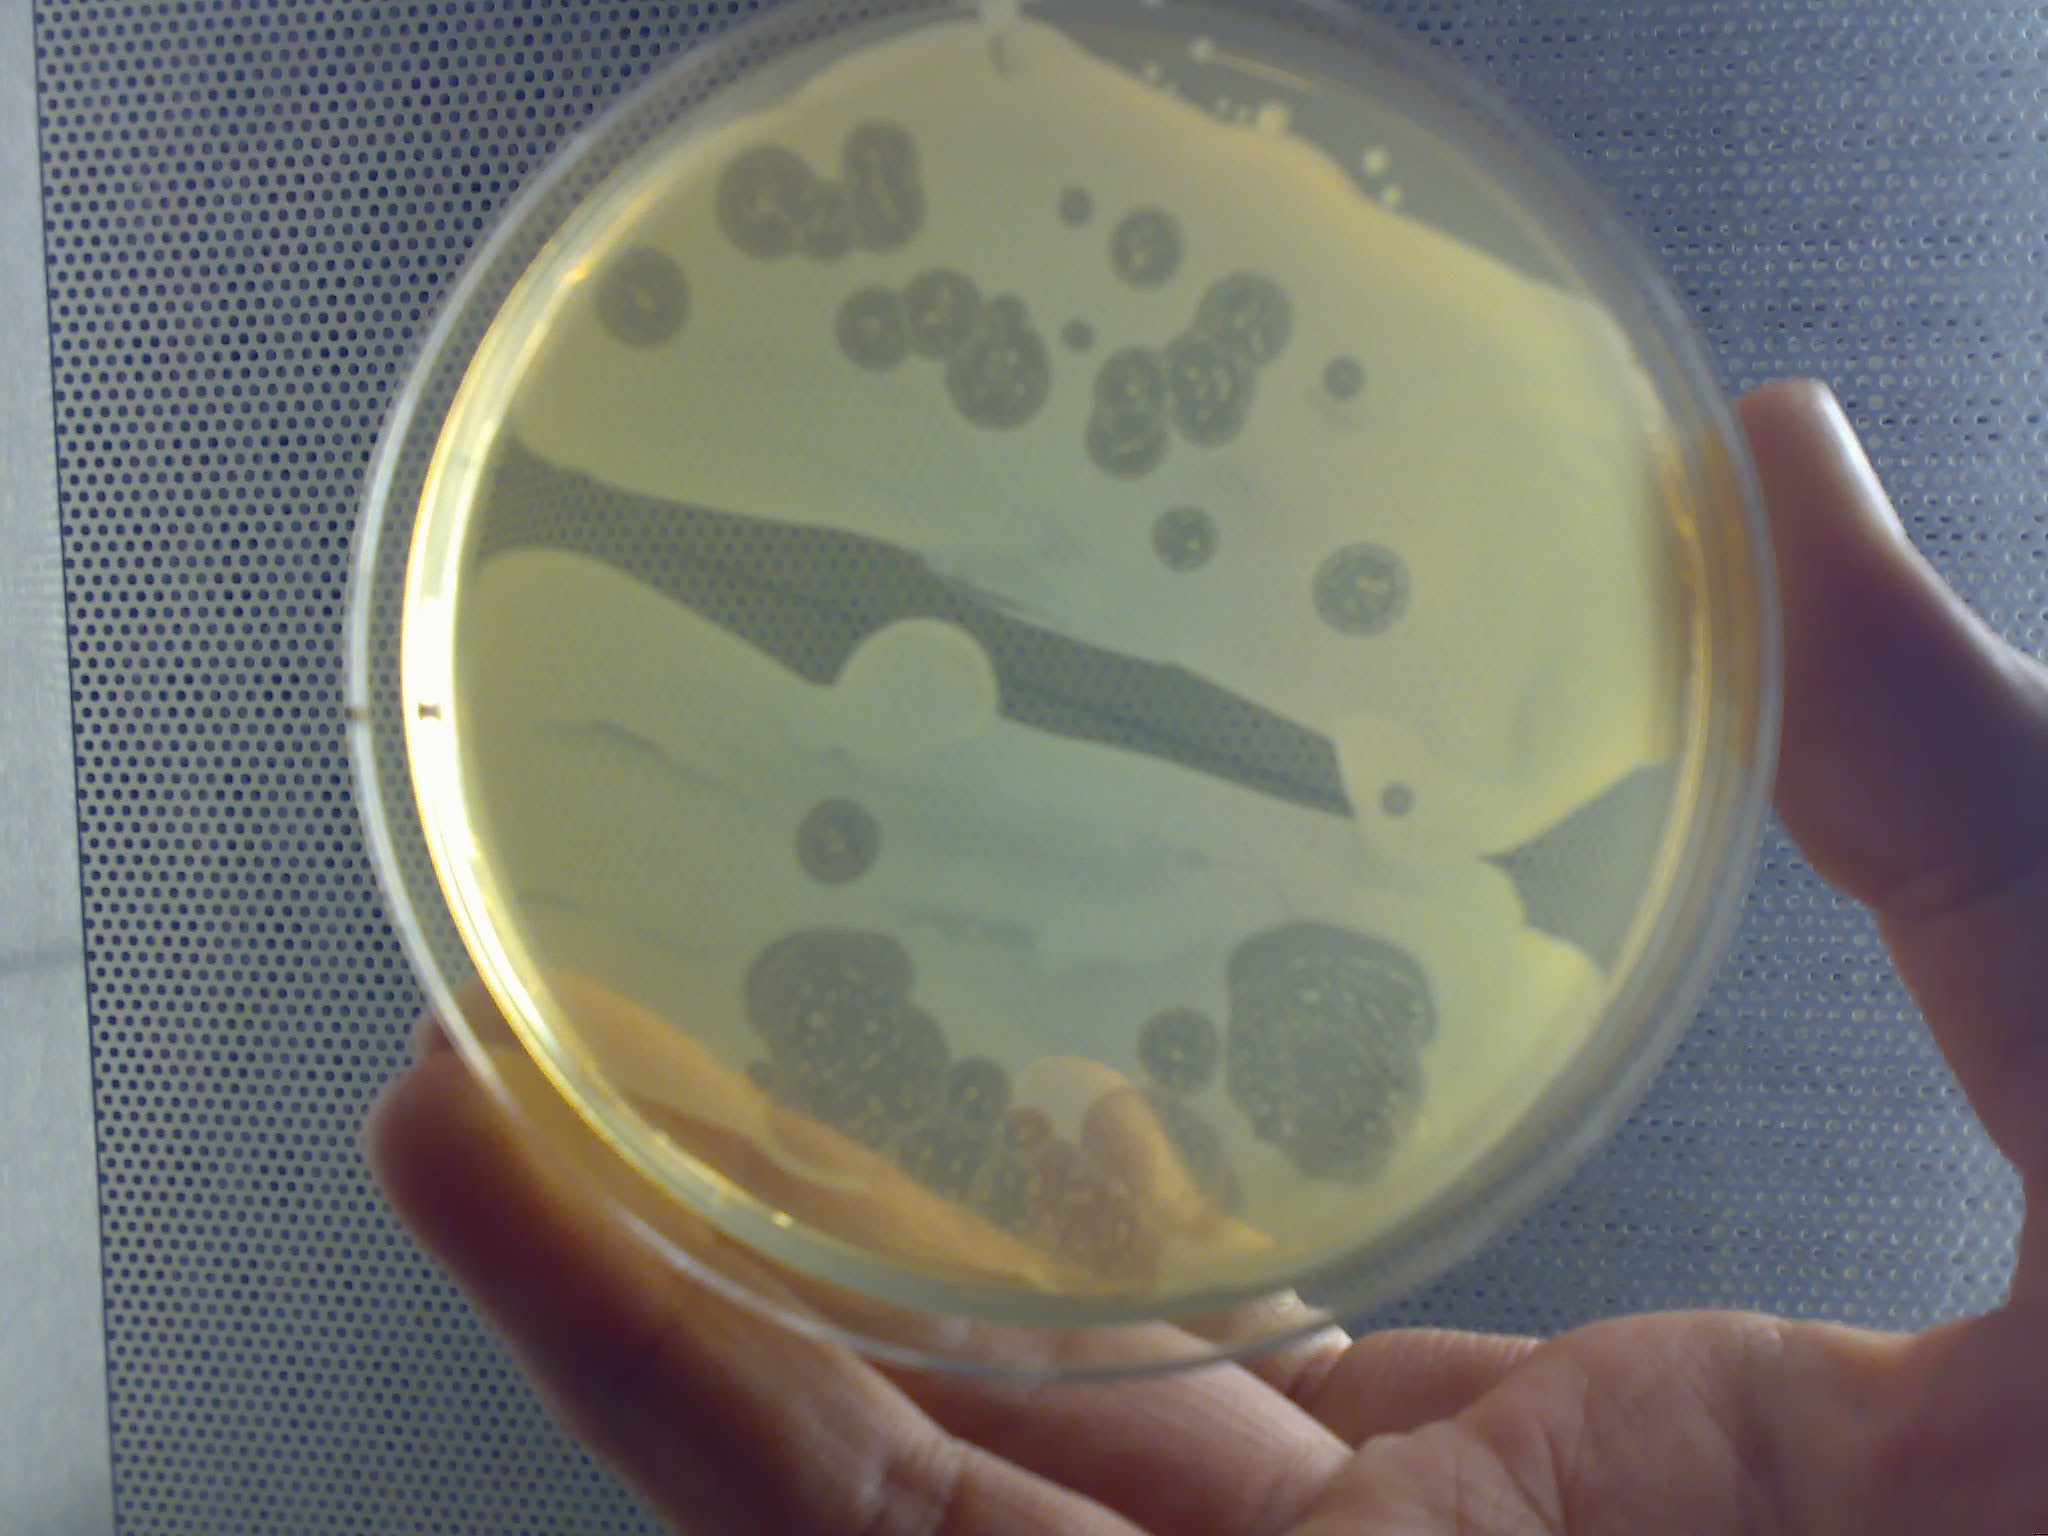

딕티오스텔리움목
"오늘의AI위키"의 AI를 통해 더욱 풍부하고 폭넓은 지식 경험을 누리세요.
1. 개요
딕티오스텔리움목은 아메바 세포 시기와 포자를 형성하는 자실체 시기를 가지는 생물이다. 이들은 세균을 포식하며, 환경이 나빠지면 집합하여 가변형체를 형성한 후 자실체를 만들고 포자를 퍼뜨린다. 딕티오스텔리움목은 무성 생식과 유성 생식을 하며, 유성 생식 시에는 아메바 세포가 융합하여 큰낭포를 형성한다. 이들은 토양에서 주로 발견되며, 전 세계적으로 분포한다. 딕티오스텔리움목의 아메바 세포는 화학 물질에 반응하여 집합하며, 이들의 생활환은 다양한 생물학적 현상을 연구하는 데 활용된다. 특히 노란점균은 모델 생물로 널리 사용되며, 의학 연구와 교육에도 활용된다.
더 읽어볼만한 페이지
- 아메바류 - 마스티그아메바목
마스티그아메바목은 민물에 서식하며 부패한 유기물이나 박테리아를 섭취하는 다양한 속과 과를 포함하는 아메바류 분류군으로, 편모를 가진 마스티그아메바속, 편모가 없는 마스티겔라속, 유기물을 섭취하는 Phreatamoeba 속, 그리고 사람에게 기생하는 엔돌리마스속과 알타미라속을 포함하는 왜소아메바과 등이 속한다. - 아메바류 - 점균류
점균류는 세포벽이 없는 다핵 원형질체를 가진 생물 다계통군으로, 헛발을 이용해 이동하며 유기물, 세균, 원생동물 등을 섭취하고, 과거 식물이나 균류로 분류되었으나 현재는 아메보조아에 속하는 진정 점균류와 다계통적인 원생 점균류 및 세포성 점균류를 포함하는 원생생물로, 약 1000여 종이 습한 환경에 서식하며 다양한 분야에서 활용된다.
2. 생활사
딕티오스텔리움은 먹이(주로 박테리아)가 풍부할 때는 개별 아메바처럼 행동하며 정상적으로 먹고 분열한다. 그러나 음식 공급이 고갈되면 집합체를 형성하여 가소성체(또는 그렉스, 슬러그)를 이룬다. 여기서 슬러그는 복족류 연체동물 민달팽이와 혼동하지 않도록 주의해야 한다. 그렉스는 전방과 후방이 뚜렷하며, 빛과 온도 기울기에 반응하고 이동할 수 있다. 적절한 상황에서 그렉스는 줄기가 하나 이상인 소러스(포자 덩어리)를 지지하는 자실체를 형성하여 성숙한다. 이 포자는 저항성 세포벽으로 보호되는 비활성 세포이며, 먹이를 구할 수 있게 되면 새로운 아메바가 된다.
''아키토스텔리움''에서 자실체는 셀룰로스로 구성된 줄기에 의해 지지되지만, 다른 딕티오스텔리움에서는 줄기가 세포로 구성되며, 때로는 원래 아메바의 대부분을 차지한다. 몇 가지 예외를 제외하고, 이 세포들은 줄기 형성 중에 죽으며, 그렉스의 부분과 자실체의 부분 사이에 명확한 상관 관계가 있다. 아메바의 응집은 일반적으로 수렴하는 흐름에서 일어난다. 아메바는 사상형 가짜발을 사용하여 이동하며 다른 아메바에서 생성된 화학 물질에 끌린다. ''Dictyostelium discoideum''에서 응집은 cAMP에 의해 신호되지만, 다른 종은 다른 화학 물질을 사용한다. ''Dictyostelium purpureum'' 종에서 그룹화는 근접성뿐만 아니라 친족 관계에 의해서도 이루어진다.
타마호코리곰팡이류는 생활환에서 단세포의 아메바 세포 시기와 포자를 형성·산포하는 자실체 시기를 가진다.[19][17][16][22][20][26] 이와는 별개로 매크로시스트(macrocyst)를 거쳐 유성 생식을 한다.
2. 1. 무성 생식
타마호코리곰팡이류는 생활환에서 단세포 아메바 세포 시기와 포자를 형성하고 산포하는 자실체가 되는 시기를 가진다.[19][17][16][22][20][26]타마호코리카비류의 영양체는 단세포, 단핵성 (핵을 1개 포함)의 아메바 세포이며, '''점균 아메바'''[17][18]라고도 불린다. 아메바 세포는 세균 등 미생물을 포식하며, 이분열로 증식한다.[16][20][26] 환경 조건이 악화되면, 셀룰로스성의 2층 세포벽을 형성하여 시스트 ('''마이크로시스트''')가 되는 경우가 있다.[19][17][20][26] 마이크로시스트는 휴면 구조이며, 환경 조건이 좋아지면 아메바 세포를 생성한다.
기아 상태 등이 되면, 아메바 세포는 집합하여 자실체 형성을 시작한다. 아메바 세포는 집합 물질 (케모어트랙턴트, 집합 페로몬)을 분비하며, 그 주화성에 의해 집합한다.[19][16][20] 이 집합 물질은 아크라신으로 통칭되지만, 점균류에서는 cAMP, 엽산, 프테린, 글로린 등 계통군에 따라 다른 물질이다.[16][26][29][51]
결국 가짜 변형체는 자루와 포자 덩어리로 구성된 자실체를 형성한다.[19][16][20] 자실체에서도 개별 세포의 독립성은 유지되며, 이러한 자실체는 '''누적 자실체'''라고도 한다. 자실체의 높이는 보통 0.2–10 mm 정도이다.[21][51] 자루가 세포성인 경우, 완성 시에는 이를 구성하는 세포는 죽는다.[26] 변형균과는 달리 포자 덩어리를 감싸는 명확한 구조는 없지만, 공통의 점액질로 덮여 있다. 포자는 발아하여 아메바 세포가 된다.[17][16][20]
2. 2. 유성 생식
아메바 세포가 박테리아 먹이 공급에 굶주리고 어둡고 습한 조건이 존재할 때 유성 생식이 발생할 수 있다.[5] 딕티오스텔리움(Dictyostelium)의 이형성 및 동형성 균주 모두 짝짓기를 할 수 있다. 이형성 유성 생식은 ''D. discoideum''에서 가장 광범위하게 연구되었으며, 동형성 유성 생식은 ''D. mucoroides''에서 가장 잘 연구되었다.[6] 이형성 짝짓기는 서로 다른 짝짓기 유형의 두 균주에서 온 반수체 세포(배우자)의 융합으로 시작된다. 이는 두 가지 짝짓기 유형을 모두 표현하는 것으로 보이는 동형성 균주와 대조된다.[7]짝짓기는 작은 이핵 세포를 형성하기 위해 융합하는 작고 운동성 있는 배우자를 생성하는 배우자 형성에 의해 시작된다. 이핵 세포의 부피는 거대 이핵 세포를 생성하기 위해 증가한다. 성장이 진행됨에 따라 핵이 부풀어 오르고 융합되어 진정한 배수체 접합자 거대 세포를 형성한다. 이러한 일이 발생하는 동안, 아메바는 cAMP 유도 주화성을 거쳐 거대 세포 표면으로 이동한다. 이것은 세포 응집체를 형성하고 응집체의 중심에서 접합자 거대 세포는 주변 아메바를 섭취한다. 포식 작용 후 섭취된 아메바의 소화가 뒤따른다. 다음으로 접합자는 주변 세포외 셀룰로오스 외피가 특징인 대낭포자를 형성한다. 대낭포자가 형성된 후에는 발아 전에 일정 기간 동안 보통 휴면 상태로 유지된다.[8] 대낭포자 내에서 배수체 접합자는 감수 분열을 거친 후 연이은 유사 분열이 일어난다. 대낭포자가 발아하면 많은 반수체 아메바 세포가 방출된다.
타마호코리곰팡이류는 그 생활환에서 단세포의 아메바 세포인 시기와 포자를 형성·산포하는 구조인 자실체가 되는 시기를 가진다.[19][17][16][22][20][26] 이와는 별개의 구조인 매크로시스트(macrocyst)를 거쳐 유성 생식을 한다.[19][17][16][22][20]
점균류에서는 유성생식도 알려져 있다(다만 유성생식이 알려지지 않은 종도 있다). 대응하는 교배형(헤테로탈리즘 또는 호모탈리즘)의 아메바 세포가 융합하여 거대 세포(giant cell)가 되고, 주변의 미융합 세포를 유인하여 포식한다(카니발리즘[22])[19][16][26][29]。이윽고 거대 세포를 포함한 세포 집괴는 셀룰로스를 포함하는 5층의 세포벽을 형성하여 '''큰낭포'''(macrocyst)라고 불리는 휴면 구조가 된다(큰낭포 내에서도 남은 미융합 세포를 포식한다)[19][17][16][26][29] 큰낭포는 발아 시 감수 분열, 그리고 이어지는 체세포 분열을 하여 다수의 아메바 세포를 방출한다.[19][17][16][29] 즉, 점균류의 생활 환에서 큰낭포만이 복상이며, 다른 기간은 모두 단상이다(단상 단세대형 생활 환).
3. 생태
점균류는 주로 토양에서 생활하며, 세균을 먹고 산다.[17][16][26][29][56][25] 점균류의 아메바 세포는 세균이 내뿜는 엽산에 이끌려 이동하는 것으로 알려져 있다.[32] 적절한 환경에서는 토양 1g당 수십에서 수천 개의 점균류 아메바 세포가 존재하며, 이들은 세균을 잡아먹어 미생물 군집의 크기와 구성에 큰 영향을 미친다.[26][27] 드물게 나무껍질, 공중에 떠 있는 낙엽, 열대 우림의 나무 위 토양에서도 발견된다.[27]
점균류는 매우 작아 자실체도 야외에서 직접 확인하기 어렵지만, 한천 배지에서 세균과 함께 토양을 배양하면 비교적 쉽게 관찰할 수 있다.[29][56] 과거에는 말의 배설물에서 처음 발견되어 배설물에 사는 생물로 오해받기도 했지만, 실제로는 배설물과 특별한 관련이 없다.[17][26] 다만, Speleostelium caveatumla (=Dictyostelium caveatumla)는 동굴 박쥐의 배설물에서 자라며, 다른 점균류의 아메바 세포를 먹이로 삼는다.[17][26][29]
점균류는 알래스카나 북유럽 등의 아한대 지역부터 열대 지역까지 전 세계에 분포한다.[26] 특히 신열대구에서 다양한 종류가 발견된다.[26][27] 고위도보다는 저위도, 고지대보다는 저지대에서 종의 수와 나타나는 빈도가 높아지는 경향을 보인다.[17][16][26][29][27] 일본에서는 추운 지역, 따뜻한 지역, 넓은 지역에 걸쳐 서식하는 종들이 알려져 있다.[56] 특히 숲 토양에 많으며, 보통 4~8종의 점균류가 발견된다.[17][16][29][26] 초원, 경작지, 사막, 툰드라 등에서도 보고된 바 있다.[17][28][29] 표층 토양(깊이 0–3 cm)에 주로 분포하며, 깊어질수록 수가 줄어들지만, 깊이 20–30 cm에서도 발견된다.[26] 다양한 토양 습도 환경에서 살아가지만, 중간 정도의 습도에서 아메바 세포 수가 가장 많다.[26][27] 약산성 숲 토양에서 종과 세포 수가 가장 많지만, 알칼리성 토양에서 자라는 종도 있다.[26] 온대 지역에서는 봄과 가을에 아메바 세포와 포자가 가장 많다.[26][27] 또한, 자라는 관다발식물의 종류와 그 토양에서 발견되는 점균류의 종류 사이에 관련이 있는 것으로 보인다.[26]
몇몇 점균류 사이에서는 이종 간 상호 작용이 알려져 있다. 흰곰팡이모기(Heterostelium pallidumla)의 아메바 세포는 다른 종의 아메바 세포를 죽이는 물질을 분비한다.[17] 다른 점균류의 아메바 세포를 잡아먹는 Speleostelium caveatumla는 먹이가 되는 점균류의 생활환 진행(자실체 형성)을 억제하는 것으로 보인다.[26]
노란균류의 일부는 포자 덩어리 안에 세균(특히 버크홀데리아속의 특정 종)을 가지고 다니는데, 이러한 특징을 가진 점균류를 '파머(farmer)'라고 부른다.[30][31] 이 세균들은 포자가 퍼진 곳에서 증식하여 포자에서 싹튼 점균 아메바의 먹이가 된다. 이러한 현상은 '원시적인 농업'이라고도 불린다. 이 세균들 중 일부는 파머에게는 해롭지 않지만, 파머가 아닌 점균류에게는 독이 되는 물질을 만들어 파머가 경쟁에서 유리하도록 돕는다.
4. 특징
딕티오스텔리움목의 아메바 세포는 사상 가짜발을 이용하여 이동하며, 세균 등을 포식한다. 환경 조건이 나빠지면 시스트(마이크로시스트)가 되기도 하는데, 이는 휴면 구조로 환경 조건이 좋아지면 다시 아메바 세포가 된다. 다만 타마호코리카비속 등에서는 마이크로시스트 형성이 발견되지 않았다.[21] 딕티오스텔리움목에서는 편모 세포가 알려져 있지 않다.[22]
음식(주로 박테리아)이 풍부할 때 딕티오스텔리움은 개별 아메바처럼 행동하며 정상적으로 먹고 분열한다. 그러나 음식 공급이 고갈되면 집합체를 형성하여 가소성체, 그렉스, 또는 슬러그(복족류 연체동물 민달팽이를 슬러그라고 부르는 것과 혼동하지 말 것)라고 불린다. 그렉스는 전방과 후방이 뚜렷하며, 빛과 온도 기울기에 반응하고 이동할 수 있다. 적절한 상황에서 그렉스는 줄기가 하나 이상인 소러스 (포자 덩어리)를 지지하는 자실체를 형성하여 성숙한다. 이 포자는 저항성 세포벽으로 보호되는 비활성 세포이며, 음식을 사용할 수 있게 되면 새로운 아메바가 된다.
''아키토스텔리움''에서 자실체는 셀룰로스로 구성된 줄기에 의해 지지되지만, 다른 딕티오스텔리움에서는 줄기가 세포로 구성되며, 때로는 원래 아메바의 대부분을 차지한다. 몇 가지 예외를 제외하고, 이 세포들은 줄기 형성 중에 죽으며, 그렉스의 부분과 자실체의 부분 사이에 명확한 상관 관계가 있다.
아메바의 응집은 일반적으로 수렴하는 흐름에서 일어난다. 아메바는 사상형 가짜발을 사용하여 이동하며 다른 아메바에서 생성된 화학 물질에 끌린다. ''Dictyostelium discoideum''에서 응집은 cAMP에 의해 신호되지만, 다른 종은 다른 화학 물질을 사용한다. ''Dictyostelium purpureum'' 종에서 그룹화는 근접성뿐만 아니라 친족 관계에 의해 이루어진다. 세포 집합은 cAMP 등 화학 물질(아크라신)에 의한 주화성으로 일어난다.
thumb
아메바 응집 기작은 신호 분자로서 cAMP에 의존한다. 집단의 창시자인 한 세포는 스트레스에 반응하여 cAMP를 분비하기 시작한다. 다른 세포들은 이 신호를 감지하고 두 가지 방식으로 반응한다.
- 아메바는 신호를 향해 이동한다.
- 아메바는 신호를 증폭시키기 위해 더 많은 cAMP를 분비한다.
이러한 작용의 결과는 근처 아메바 집단 전체에 신호를 전달하고 cAMP 농도가 가장 높은 영역으로 내향 이동을 유발한다.
개별 세포 내에서 기작은 다음과 같다.
# 세포막에서 cAMP 수용은 G 단백질을 활성화한다.
# G 단백질은 아데닐산 시클라제를 자극한다.
# cAMP는 세포 밖으로 확산되어 배지로 들어간다.
# 내부 cAMP는 외부 cAMP 수용체를 비활성화한다.
# 다른 G 단백질은 포스포리파아제 C를 자극한다.
# IP3는 칼슘 이온 방출을 유도한다.
# 칼슘 이온은 세포 골격에 작용하여 위족 확장을 유도한다.
내부 cAMP 농도가 외부 cAMP 수용체를 비활성화하기 때문에 개별 세포는 진동적 행동을 보인다. 이러한 행동은 수렴하는 집락에서 볼 수 있는 아름다운 나선을 만들어내며, 이는 벨로우소프-자보틴스키 반응 및 2차원 순환 세포 오토마타를 연상시킨다.
자실체는 자루와 포자 덩어리로 구성되며, 자루는 세포성 또는 비세포성이다.
원통별아메바 전체 유전체는 2005년 유전학자 루드비히 아이힝거와 동료들에 의해 네이처에 발표되었다.[4] 단상 유전체는 6개의 염색체에 약 12,500개의 유전자를 포함하고 있다. 비교를 위해, 배수체 인간 유전체는 23쌍의 염색체에 20,000-25,000개의 유전자(두 번 표현됨)를 가지고 있다. 아데노신과 티미딘(~77%)의 높은 수준은 세 번째 위치에서 더 많은 아데노신과 티미딘을 선호하는 코돈 사용으로 이어진다. 삼염기체 반복은 원통별아메바에 풍부하며, 이는 인간에게서 삼염기체 반복 질환을 유발한다.
5. 분류
딕티오스텔리움목의 계통 발생수는 지난 수십 년 동안 여러 번 변경되었다. 최초로 기술된 딕티오스텔리드는 1869년 오스커 브레펠드가 기술한 ''Dictyostelium mucoroides''였으며, 1935년에 ''Dictyostelium discoideum''이 처음 발견되었다.[9] 이후 케네스 레이퍼의 추가 발견과 제임스 캐번더와 협력자들의 노력이 이어졌다. ''Dictyostelium discoideum''은 처음에는 '하등 균류'로 분류되었지만, 이후 분류가 바뀌어 현재는 아메바생물문(Amoebozoa phylum)에 속하게 되었다.[4]
딕티오스텔리드 계통 발생수 내의 그룹들은 새로운 증거에 따라 자주 재정렬되었다. 현재 가장 일반적으로 받아들여지는 딕티오스텔리드의 계통 발생수는 게놈 시퀀싱과 소단위 리보솜 DNA(ssu-rDNA)를 활용한다. 딕티오스텔리드는 네 개의 그룹으로 더 세분될 수 있는데, 특히 4군은 ''Dictyostelium discoideum'' 종을 포함하며, 집합 동안 방출되는 유인 물질로 cAMP를 사용하는 점에서 다른 그룹들과 차이가 있다.[10]
화석에 따른 연대 측정 결과, 딕티오스텔리드강은 약 5억 2천만 년 전에 두 개의 주요 분기로 처음 분화되었다. 딕티오스텔리드 줄기 및 포자 형성은 원래 지구의 빙하 형성에 대한 적응으로 진화했으며, 대부분의 빙하 지형이 녹으면서 딕티오스텔리드 종의 추가적인 세분화가 일어났을 가능성이 높다. 주요 그룹 1, 2, 3의 대부분의 종은 개체가 저온에서 생존할 수 있도록 하는 낭포화 능력을 보이지만, 포자는 저온 저항 능력이 더 뛰어난 것으로 나타났다. 그룹 4는 낭포화 능력이 일반적으로 부족하다는 점에서 다른 주요 그룹과 다르지만, 이 그룹의 포자는 다른 그룹의 포자에 비해 저온에 대한 저항력이 더 우수한 것으로 나타났다.[11]
반 티검 (1880)은 자실체 형성 시에 형성되는 구조가 변형체(다핵의 단일 원형질)가 아니라 다세포체(가변형체)임을 밝혀, 타마호코리카비류를 변형균과는 다른 분류군(세포성 점균)으로 분류했다.[16][20][26][35][36][37] 1899년 시바타 게이타는 말의 배설물에서 Polysphondylium violaceumla를 분리하여 무라사키카비모도키라는 일본 이름을 붙였는데, 이것이 일본에서 타마호코리카비류의 첫 번째 기록이다.[25][38]
세포성 점균은 변형균과 함께 광의의 변형균문(점균)으로 분류되는 경우가 많았다.[19][39][40] 점균은 균류(진균)와 유사한 자실체를 형성하므로 균류로 분류되었지만, 영양체가 세포벽을 갖지 않는 아메바 세포이므로 균류(진균)와의 유연성은 의문시되는 경우도 많았다.[19]
20세기 말 이후 분자 계통학 연구에 의해, 세포성 점균을 포함하는 광의의 변형균문(점균)이 균류와는 계통적으로 무관계하고, 세포성 점균이 다계통군이라는 것이 밝혀졌다.[43][44] 결국 타마호코리카비류는 진핵생물의 대계통군 중 하나인 아메바류에 속하며, 특히 변형균(진정 점균)과 원생 점균의 일부(츠노호코리류)에 근연임이 밝혀졌다.
분류학적으로 타마호코리카비류는 아메바류문 내의 독립강인 '''타마호코리카비강''' 또는 진정동균강의 한 아강인 '''타마호코리카비아강'''으로 분류된다(2020년 현재).[29][52][53]
5. 1. 분류 체계 (2018년 기준)
6. 인간과의 관계
딕티오스텔리움은 분자 생물학과 유전학 분야에서 모델 생물로 사용되며, 세포 간 신호 전달, 세포 분화, 세포 자멸사를 연구하는 데 쓰인다. 또한 협력과 속임수의 진화에 대한 흥미로운 사례이기도 하다.[1][2][3]
노란점균을 비롯한 점균류는 이질 아메바, 아칸토아메바 같은 아메바류 병원성 종 연구에 비교 생물로, 포유류 면역 반응 연구에 이용된다.[26] 또한 점균류에서 분리된 생리 활성 물질은 신약 개발 자원으로도 주목받는다.[33]
세포성 점균류의 독특한 생활사는 생물학 교육 교재로 활용될 수 있다.[56]
6. 1. 모델 생물
딕티오스텔리움은 분자 생물학과 유전학 분야에서 모델 생물로 사용되어 왔으며, 세포 간 신호 전달, 세포 분화, 세포 자멸사의 예시로서 연구된다. 또한 협력과 속임수의 진화에 대한 흥미로운 사례이기도 하다.[1][2][3]특히 노란점균(''Dictyostelium discoideum'')은 배양이 용이하고 세균을 포함하지 않는 순수 배양이 가능하다는 점, 생활환 완료가 단시간에 조절 가능하다는 점, 게놈 크기가 비교적 작다는 점, 유전자 도입 등이 용이하며, 다양한 분자생물학적 기법이 확립되어 있다는 점 때문에 모델 생물로 널리 이용되고 있다.[26][32] ''D. discoideum''에 관한 방대한 연구 데이터는 DictyBase에서 온라인으로 이용 가능하다.
노란점균을 포함한 수 종에서 게놈 염기 서열이 보고되었으며, 이러한 게놈 데이터는 데이터베이스([http://dictybase.org/ dictyBase])에 정리되어 있다. 또한 몇몇 종의 배양주와 변이체, 벡터, 플라스미드, cDNA 등의 구입 환경도 정비되어 있다 ([https://nenkin.nbrp.jp/ NBRP Nenkin]).
6. 2. 의학 연구
노란점균을 비롯한 점균류는 의학 연구에 이용된다. 아메바류에 속하는 병원성 종인 이질 아메바, 아칸토아메바 연구 시 점균류가 비교 생물로 사용된다.[26] 점균류는 림프구 운동이나 대식세포의 탐식 작용 등 포유류 면역 반응 연구에도 이용된다.[26] 또한 점균류에서 분리된 여러 생리 활성 물질은 신약 개발 자원으로도 주목받는다.[33]6. 3. 기타
세포성 점균류의 독특한 생활사는 생물학 교육 교재로 활용될 수 있다.[56]참조
[1]
논문
Altruism and social cheating in the social amoeba ''Dictyostelium discoideum''
2000
[2]
논문
Developmental cheating and the evolutionary biology of ''Dictyostelium'' and ''Myxococcus''
2000
[3]
논문
Evolutionary dynamics of altruism and cheating among social amoebas
2005
[4]
논문
The genome of the social amoeba Dictyostelium discoideum
[5]
논문
Variation, sex, and social cooperation: molecular population genetics of the social amoeba Dictyostelium discoideum
2010-07
[6]
논문
Signalling and sex in the social amoebozoans
2012-05
[7]
논문
The mating system of the cellular slime mould Dictyostelium discoideum
1980-04
[8]
논문
Macrocysts in the life cycle of Dictyostelliaceae II. Germination of the macrocysts
1973
[9]
논문
Ein neuer Organismus und der Verwandschaft der Myxomyceten
[10]
논문
A well supported multi gene phylogeny of 52 dictyostelia
2019
[11]
논문
Cold climate adaptation is a plausible cause for evolution of multicellular sporulation in Dictyostelia
https://rdcu.be/cZx2[...]
2020-05-29
[12]
논문
A New Classification of the Dictyostelids
https://doi.org/10.1[...]
2017-11-24
[13]
논문
Outline of Fungi and fungus-like taxa
[14]
서적
"''Legionella'': Molecular Microbiology"
Caister Academic Press
[15]
논문
原生生物の多様性
https://agriknowledg[...]
[16]
서적
バイオディバーシティ・シリーズ (4) 菌類・細菌・ウイルスの多様性と系統
裳華房
[17]
서적
菌類の事典
朝倉書店
[18]
서적
岩波 生物学辞典 第5版
岩波書店
[19]
서적
ウェブスター菌類概論
講談社サイエンティフィク
[20]
서적
Introductory Mycology
John Wiley & Sons. Inc., New York
[21]
논문
Analysis of phenotypic evolution in Dictyostelia highlights developmental plasticity as a likely consequence of colonial multicellularity
[22]
서적
菌類のふしぎ 形とはたらきの驚異の多様性
東海大学出版会
[23]
웹사이트
ナショナルバイオリソースプロジェクト「細胞性粘菌」
http://shigen.nig.ac[...]
国立遺伝学研究所・生物遺伝資源情報総合センター
2008-03-31
[24]
서적
岩波 生物学辞典 第5版
岩波書店
[25]
논문
細胞性粘菌の系統と発生
[26]
서적
Handbook of the Protists
Springer
[27]
서적
Biodiversity of Fungi: Inventory and Monitoring Methods
Elsevier, Academic Press
[28]
서적
バイオディバーシティ・シリーズ (4) 菌類・細菌・ウイルスの多様性と系統
裳華房
[29]
서적
Syllabus of Plant Families. A. Engler's Syllabus der Pflanzenfamilien Part 1/1
Borntraeger
[30]
논문
Primitive agriculture in a social amoeba
[31]
논문
"''Burkholderia'' bacteria infectiously induce the proto-farming symbiosis of Dictyostelium amoebae and food bacteria"
[32]
논문
細胞性粘菌リソースの研究への利用
https://bsj.or.jp/jp[...]
[33]
서적
細胞性粘菌 : 研究の新展開 : モデル生物・創薬資源・バイオ
アイピーシー
[34]
논문
Dictyostelium mucoroides. Ein neuer Organismus aus der Verwandtschaft der Myxomyceten
https://www.biodiver[...]
[35]
논문
A brief history of the cellular slime molds
https://www.fungimag[...]
[36]
논문
粘菌門の生物学
[37]
논문
Sur quelques Myxomycètes á plasmode agrège
[38]
논문
下等変形菌ポリスフホンディリウム
[39]
서적
植物系統分類の基礎
北隆館
[40]
서적
バイオディバーシティ・シリーズ (4) 菌類・細菌・ウイルスの多様性と系統
裳華房
[41]
서적
バイオディバーシティ・シリーズ (5) 無脊椎動物の多様性と系統
裳華房
[42]
서적
Syllabus of Plant Families. A. Engler's Syllabus der Pflanzenfamilien Part 1/1
Borntraeger
[43]
서적
Syllabus of Plant Families. A. Engler's Syllabus der Pflanzenfamilien Part 1/1
Borntraeger
[44]
서적
Dictyostelids: Evolution, Genomics and Cell Biology
Springer
[45]
논문
Deep phylogeny and evolution of slime moulds (Mycetozoa)
[46]
논문
Between a pod and a hard test: the deep evolution of amoebae
[47]
논문
Molecular phylogeny and evolution of morphology in the social amoebas
[48]
논문
A well supported multi gene phylogeny of 52 dictyostelia
[49]
논문
Additional new species suggest high dictyostelid diversity on Madagascar
[50]
논문
A deep hidden diversity of Dictyostelia
[51]
논문
A new classification of the dictyostelids
[52]
논문
A revised six‐kingdom system of life
[53]
서적
岩波 生物学辞典 第5版
岩波書店
[54]
웹사이트
The MycoBank engine and related databases
https://www.mycobank[...]
Robert, V., Stegehuis, G. & Stalpers, J.
2020-11-21
[55]
논문
Kingdom protozoa and its 18 phyla
[56]
논문
生物教育のための細胞性粘菌の分類の実践
[57]
논문
Acytostelium leptosomum'': a unique cellular slime mould with an acellular stalk
[58]
문서
국제동물명명규약
[59]
문서
국제식물명명규약
본 사이트는 AI가 위키백과와 뉴스 기사,정부 간행물,학술 논문등을 바탕으로 정보를 가공하여 제공하는 백과사전형 서비스입니다.
모든 문서는 AI에 의해 자동 생성되며, CC BY-SA 4.0 라이선스에 따라 이용할 수 있습니다.
하지만, 위키백과나 뉴스 기사 자체에 오류, 부정확한 정보, 또는 가짜 뉴스가 포함될 수 있으며, AI는 이러한 내용을 완벽하게 걸러내지 못할 수 있습니다.
따라서 제공되는 정보에 일부 오류나 편향이 있을 수 있으므로, 중요한 정보는 반드시 다른 출처를 통해 교차 검증하시기 바랍니다.
문의하기 : help@durumis.com
